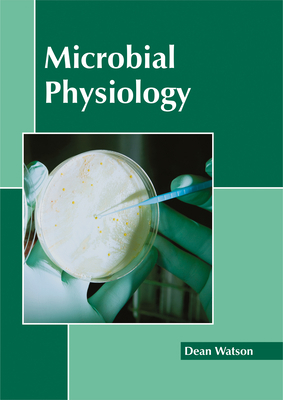
Microbial Physiology 1632398095 Book Cover

This book unravels the recent studies in the field of microbial physiology. It also provides interesting topics for research which readers can take up. Microbial physiology refers to the biochemical examination of the microbial cell functions. It also includes an in-depth study...

The Fourth Edition of Microbial Physiology retains the logical, easy-to-follow organization of the previous editions. An introduction to cell structure and synthesis of cell components is provided, followed by detailed discussions of genetics, metabolism, growth, and regulation...

Microbial physiology, the understanding of cell structure, growth factors, metabolism and genetic composition of microorganisms, is a field that is experiencing growth and strong interest. However, there is a lack of solid, comprehensive, and current reference books covering...

Microbial physiology, the understanding of cell structure, growth factors, metabolism and genetic composition of microorganisms, is a field that is experiencing growth and strong interest. However, there is a lack of solid, comprehensive, and current reference books covering...

Microbial physiology, the understanding of cell structure, growth factors, metabolism and genetic composition of microorganisms, is a field that is experiencing growth and strong interest. However, there is a lack of solid, comprehensive, and current reference books covering...
